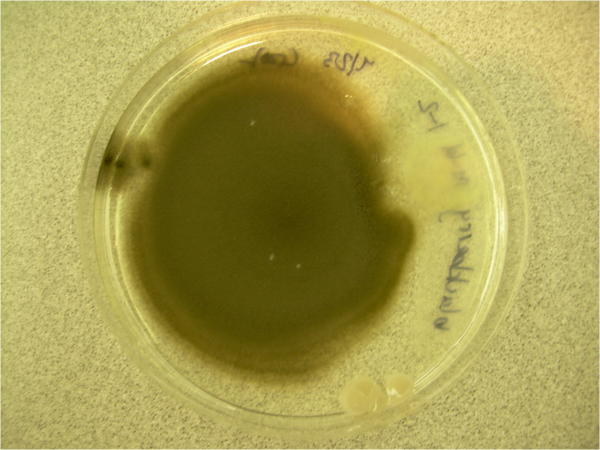

Ауреобазидиум почкующийся
Ауреобази́диум почку́ющийся (лат. Aureobasídium púllulans; (de Bary) G. Arnaud, 1918) — вид грибов-аскомицетов из рода Ауреобазидиум (Aureobasidium), входящий в семейство Saccotheciaceae порядка Дотидеевые (Dothideales). Тёмноокрашенный гриб, образующий дрожжеподобные почкующиеся конидии. Используется в биотехнологии для синтеза пуллулана.
Что важно знать
| Ауреобазидиум почкующийся | |
|---|---|
| Научная классификация | |
|
Домен: Царство: Подцарство: Отдел: Подотдел: Класс: Подкласс: Порядок: Семейство: Род: Вид: Ауреобазидиум почкующийся |
|
| Международное научное название | |
| Aureobasidium pullulans (de Bary) G. Arnaud, 1918[1] | |
| Синонимы | |
Описание
Вегетативные гифы 2—10 (12) мкм толщиной, гиалиновые. Отдельные клетки преобразуются в округлые чёрно-коричневые толстостенные бластоспоры и хламидоспоры. Растущие гифы неправильно дихотомически ветвящиеся. Конидиеносцы не выражены, фиалиды морфологически сходны с остальными клетками гиф, образуются интеркалярно в виде небольших бугорков на гифах толщиной 5—8 мкм. Конидии дрожжеподобные: первичные образуются на фиалидах, вторичные отпочковываются от первичных. Конидии неокрашенные или бледные, одноклеточные, разнообразных формы и размера, первичные достигают 10—16×3—6 мкм, вторичные мельче — 7—10×4—5 мкм. Некоторые конидии образуются эндогенно.
Колонии на агаре Чапека с дрожжевым экстрактом (CYA) и агаре с солодовым экстрактом (MEA) 25—35 мм в диаметре, низкие, слизистые, сначала беловатые, затем розоватые и серо-коричневые до почти чёрных, вскоре покрытые слизистым экссудатом. Колонии на 25%-но-глицериново-нитратном агаре (G25N) 10—12 мм в диаметре. При +5 °C образуются микроколонии не более 3 мм в диаметре. Приводятся данные о наличии роста у культур при температурах от +2 до +35 °C. Температурный оптимум — +25 °C. При +37 °C рост отсутствует. Возможно, некоторые штаммы способны расти при температурах до −5 °C.
Согласно молекулярно-филогенетическим данным, изоляты Aureobasidium pullulans из разных регионов образуют однородную близкую группу, что позволяет предположить полное отсутствие у гриба полового размножения.
Биология и геномика
Исследования XXI века, в особенности полногеномное секвенирование нескольких штаммов A. pullulans, выявили высокое генетическое разнообразие внутри вида[2]. Анализ показал, что различия между некоторыми ранее известными разновидностями настолько велики, что они были переклассифицированы в отдельные виды, такие как A. melanogenum, A. subglaciale и A. namibiae[2]. С помощью анализа геномов, транскриптомов и секретомов были идентифицированы многочисленные гены, ответственные за биоконтрольные свойства гриба. В геномах обнаружены кластеры генов биосинтеза вторичных метаболитов (до 25 кластеров в одном штамме), а также сотни генов, кодирующих секретируемые гидролитические ферменты (эстеразы, гликозилазы, пептидазы), которые играют ключевую роль в подавлении фитопатогенов[2]. В 2024 году у штамма CG163, используемого в коммерческих биопрепаратах, были обнаружены два уникальных кластера генов, отвечающих за синтез гибридных поликетидов и нерибосомных пептидов[3].
A. pullulans демонстрирует высокую пластичность и способность адаптироваться к различным условиям окружающей среды. В 2023 году исследование транскриптома показало, что гриб радикально меняет свою морфологию и экспрессию генов в ответ на изменение pH. В кислой среде (pH 4.0) преобладает гифальный рост, в нейтральной (pH 7.0) — образование толстостенных спор, а в щелочной (pH 10.0) — рост в виде удлинённых дрожжеподобных клеток. Гриб также регулирует синтез пуллулана, меланина и полималиевой кислоты в зависимости от кислотности среды[4]. Кроме того, гриб способен повышать устойчивость растений к засухе. При обработке саженцев корейской пихты (Abies koreana) A. pullulans модулировал микробиом ризосферы и изменял экспрессию генов в самом растении, что приводило к усилению защитных механизмов от стресса[5].
Ареал и экология
Повсеместно распространённый гриб-сапротроф. Встречается на самых разнообразных влажных гниющих субстратах, в почве, на листьях растений и внутри них, редко — на пищевых продуктах.
Значение
Aureobasidium pullulans — природный источник полисахарида пуллулана. Синтезирует пуллулан только при избытке подходящего источника углерода.
Кроме того, гриб активно используется в биологическом контроле заболеваний растений. Его эффективность основана на нескольких механизмах: конкуренция за питательные вещества и пространство, индукция системной устойчивости у растений-хозяев, а также выработка литических ферментов (например, протеаз), разрушающих клеточные стенки патогенов, и противогрибковых метаболитов (таких как экзофилины и лиамоцины)[6]. В 2023 году была подтверждена его эффективность против Colletotrichum acutatum, возбудителя антракноза клубники[6].
Штаммы A. pullulans нашли применение и в виноделии. Благодаря способности выделять пектинолитические ферменты, они используются при совместной ферментации с дрожжами Saccharomyces cerevisiae для улучшения цвета и органолептических свойств вин[7]. Гриб также является продуцентом холодоактивных ферментов, которые могут применяться в пищевой промышленности для обработки продуктов при низких температурах[8].
Синонимы
Гомотипные:
- Anthostomella pullulans (de Bary) F.T.Benn., 1928
- Cladosporium pullulans (de Bary) Sacc. & Trotter, 1913
- Dematium pullulans de Bary, 1866basionym
- Hormonema pullulans (de Bary) Lagerb. & Melin ex Robak, 1932
- Pullularia pullulans (de Bary) Berkhout, 1923
Гетеротипные:
- Aureobasidium oleae
- Aureobasidium vitis Viala & G.Boyer, 1891typus
- Aureobasis vitis (Viala & G.Boyer) Clem. & Shear, 1931
- Candida malicola
- Chrysobasidium vitis (Viala & G.Boyer) Clem., 1909
- Dematoidium nigrescens[9]
- Exobasidium vitis (Viala & G.Boyer) Prill. & Delacr., 1894
- Hormonema oleae
- Kabatiella lini
- Polyspora lini
Примечания
Литература
- Беломесяцева Д. Б., Шабашова Т. Г. Флора Беларуси. Грибы. — Минск, 2015. — Т. 2. Анаморфные грибы. Кн. 1. Тёмноокрашенные гифомицеты. — С. 49—50. — ISBN 978-985-08-1835-5.
- Hoog G. S. de. Atlas of Clinical Fungi. — Utrecht, 2000. — P. 520. — ISBN 978-90-70351-43-4.
- Pitt J. I., Hocking A. D. Fungi and Food Spoilage. — London, 1997. — P. 76—77. — ISBN 978-0-8342-1306-7.